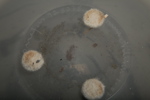
Orrefors "Graal", Vas

505 Orrefors "Graal", Vas

- Design: Signerad Anne Nilsson
- H= 20cm
- Dia= 14cm
- Condition:Bruksslitage.
| Buyers Premium (inc. VAT) | 15% |
| Hammer Fee (inc. VAT) | 50 SEK |
| Shipping Fee (from) | 219 SEK |

Address
Bergviks Auktionstjänst i Söderhamn AB
Bäckforsvägen 11
826 67 Bergvik
© Software Copyright 2025 Skeleton. All rights reserved.